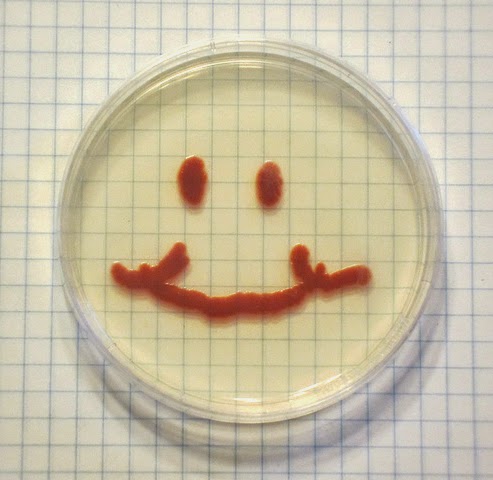

Are you working in a healthy research laboratory culture? (Sam Manna)
![]() |
| Photo by benandclare | www.flickr.com/photos/benandclare CC license: creativecommons.org/licenses/by-nc-nd/2.0 |
Some people say that it’s the supervisor’s responsibility to maintain a healthy research laboratory culture.
While this may be true, it’s likely that it’s the last thing your supervisor is thinking about.
This means that maintaining a healthy research laboratory culture falls to the laboratory members. But what exactly do I mean by a “healthy research laboratory culture”?
Let me put it this way: Do you hate going into the lab in the morning? Are there people in your lab that you don’t get along with? Do you count down the hours until it’s 5pm and you can go home (not that 5pm is really a time any PhD student leaves the lab anyway!)?
If you answered ‘yes’ to any of these, the culture in your lab may not be very healthy, which can affect productivity.
In this post, I wanted to talk about some tips that will create a positive vibe in the lab. As a molecular biologist, my perspective on this is for biological laboratories, but I think these tips apply to any laboratory.
Spend time with your lab, outside of the lab!
It shouldn’t surprise you that developing positive relationships with the people in your lab is one of the strongest ways to create a healthy lab culture.
The easiest way to do this is for the lab to spend some time together outside of the lab.
During my PhD, 10.30am every day was coffee time. I and other members of the lab would purposely plan our experiments so that we would be free at this time to head down to the local coffee place for a 20-minute break together. Additionally, we discussed our projects on a regular basis, so there were days when these breaks would become mini lab meetings, and lead to various ideas that we could implement in our research. We also invited our supervisor for coffee on occasion, which was an informal way of getting to talk to him.
Social outings are also a good idea. My lab has gone on picnics on a sunny afternoon, dinner at a restaurant, and even laser tag! Spending this time together will improve your relationships and make them more honest.
If you encounter any issues with one another, you will be more willing to discuss them openly and resolve them, rather than allowing them to fester and produce a negative environment in the lab.
Help each other out!
In biological research, working as part of a collaborative team is essential.
After developing the positive relationships I described earlier, you will hopefully feel more inclined to help each other. This can be as simple as bouncing ideas for experiments off of one another and getting honest feedback, or asking for help with a method someone else has experience with.
Also, working on projects together will facilitate creating a healthy culture in the lab. During my PhD, I asked a couple of fellow lab members if they would be interested in doing a couple of experiments with me. This improved the environment in the lab and led to publications on which my lab members were co-authors.
Some labs will have students in competition with one another working on a similar, or the same, project. Clearly, this will create a very unfriendly environment.
Working as a productive member of a team will not only improve the culture in the lab, but also help you develop as a researcher, so it’s a win-win situation. Helping other people in the lab will also make you feel good about yourself, and happy people lead to a happy lab!
Supervisors – encourage your students to think for themselves!
The attitude and behaviour of your supervisor is critical to how you feel and affects your work motivation.
If you have a supervisor that is autocratic and unwilling to listen to what you have to say, I can’t imagine the lab culture will be all that positive.
On the other hand, a supervisor that is encouraging and allows you to think for yourself will create a far more constructive atmosphere. Your supervisor should let you design some of your own experiments, plan your publications, and listen to your ideas.
If you feel your supervisor is hearing you and is allowing you to self-develop as a researcher, you and other members in the lab will be happier. Developing a relationship with your supervisor will facilitate this, especially if you go on those coffee breaks together!
————-
So, the occasional coffee, helping and working with your colleagues, and having an encouraging supervisor can revolutionise the environment in your lab. This, in turn, will have a significantly positive impact on everyone’s morale, leading to higher productivity and a far more enjoyable experience.
————————-
Sam Manna is a molecular biologist and recently completed his PhD (2010-2014) in mitochondrial genetics at the Department of Microbiology, La Trobe University.
He also holds a Bachelor of Biological Sciences with Honours (La Trobe University, 2006-2009). Sam’s work has been presented at several conferences and published in international journals.
He has worked in the Department of Microbiology as an Associate Lecturer, supervised honours research projects and lectured in microbial genetics and infectious diseases to undergraduate microbiology students.
Sam tweets at @sam_manna3.
Keep up to date
Find out more about Research Education and Development at La Trobe.